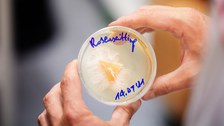
IHI 3

Studienangebot
Inhaltsverzeichnis
- Architektur und Landschaft
- Bauingenieurwesen
- Umweltwissenschaften ─ Forstwissenschaften
- Umweltwissenschaften ─ Geowissenschaften
- Umweltwissenschaften ─ Hydrowissenschaften
- Verkehrswissenschaften
- Wirtschaftswissenschaften
- Internationales Hochschulinstitut (IHI Zittau)
- Zentrale Beratungsangebote der TU Dresden
Ein Studium im Bereich Bau und Umwelt führt Sie zu einer Vielfalt von Inhalten mit sehr interessanten und wichtigen interdisziplinären Verknüpfungen. Ihnen steht eine fundierte fachliche Ausbildung bevor, in der Sie die Chance haben, sich mit uns zusammen optimal auf das spätere Berufsleben vorzubereiten. Stöbern Sie hier zu Ihren Interessen und/oder lassen Sie sich gerne beraten.
Architektur und Landschaft

© Raumgestaltung

© inst. AL

© Cornelia Grohmann
Architektinnen und Architekten erschaffen Lebensräume. Ausgehend von der Kerntätigkeit des Entwerfens synthetisieren, kontextualisieren und gestalten wir komplexe räumliche Lösungen. Im Spannungsfeld zwischen Bewahren und Transformieren der gebauten Umwelt geht das Architekturstudium weit über die Gestaltung einzelner Gebäude und baulicher Anlagen hinaus und umfasst auch den Städtebau sowie die Stadt und Raumplanung. Die Lehre und Forschung orientieren sich über die Grundlagenvermittlung und -forschung hinaus besonders an den globalen Herausforderungen des 21. Jahrhunderts. Das Studium gliedert sich in Grund- und Hauptstudium über insgesamt 11 Semester. Wahlweise können vertiefende Studien zur speziellen Gebäudeplanung, zur Stadt- und Raumplanung sowie zur Denkmalpflege durchgeführt werden.
Interessiert?
Auf der Webseite der Fakultät Architektur und Landschaft erhalten Sie detaillierte Informationen zum Diplomstudiengang Architektur, z. B. zu den Zielen des Studiengangs, zu Lehrveranstaltungen und Stundenplänen, aber auch zu Berufsperspektiven.
Im zentralen Studieninformationssystem (SINS) finden Sie weitere wichtige Bedingungen zum Studiengang, wie z. B. Studienvoraussetzungen, die verbindlichen Bewerbungsfristen und den Link zur Bewerbung.
Im Bachelor-Studiengang werden wissenschaftliche, planerische und entwerferische Grundkenntnisse und Fertigkeiten vermittelt. Das sechssemestrige Bachelor-Studium Landschaftsarchitektur vermittelt die Kenntnis wesentlicher ökologischer, sozialer und städtebaulicher Faktoren und ihres Zusammenwirkens in Landschaft und Freiraum sowie die Fähigkeit, den Bestand von Landschaft und Freiraum mit wissenschaftlichen und planerischen Methoden zielgerichtet zu erfassen und zu beurteilen. Es werden ferner geübt die Kenntnis wesentlicher historischer, rechtlicher, technisch-konstruktiver Grundlagen auf unterschiedlichen räumlichen Ebenen zur Lösung landschaftsarchitektonischer Aufgaben einzusetzen.
Interessiert?
Auf der Webseite der Fakultät Architektur und Landschaft erhalten Sie detaillierte Informationen zum Bachelorstudiengang Landschaftsarchitektur, z. B. zu den Zielen des Studiengangs, zu Lehrveranstaltungen und Stundenplänen, aber auch zu Berufsperspektiven.
Im zentralen Studieninformationssystem (SINS) finden Sie weitere wichtige Bedingungen zum Studiengang, wie z. B. Studienvoraussetzungen, die verbindlichen Bewerbungsfristen und den Link zur Bewerbung.
Das Master-Studium bereitet auf die Arbeit als selbstständiger Landschaftsarchitekt, auf eine Tätigkeit in Forschung und Entwicklung sowie auf eine Führungsposition in Management und Verwaltung von öffentlichen und privaten Freiräumen vor. Das viersemestrige forschungsorientierte konsekutive Master-Studium Landschaftsarchitektur vermittelt vertiefend die Fähigkeit zur Gestaltung und Entwicklung von Freiräumen und Landschaften auf verschiedenen räumlichen Ebenen und qualifiziert zum selbstständigen und verantwortlichen planerischen, gestalterischen und wissenschaftlichen Arbeiten. Im Studium werden komplexe ökologische, soziale und städtebauliche Zusammenhänge und ihre Auswirkung auf Landschaft und Freiraum vermittelt.
Interessiert?
Auf der Webseite der Fakultät Architektur und Landschaft erhalten Sie detaillierte Informationen zum Masterstudiengang Landschaftsarchitektur, z. B. zu den Zielen des Studiengangs, zu Lehrveranstaltungen und Stundenplänen, aber auch zu Berufsperspektiven.
Im zentralen Studieninformationssystem (SINS) finden Sie weitere wichtige Bedingungen zum Studiengang, wie z. B. Studienvoraussetzungen, die verbindlichen Bewerbungsfristen und den Link zur Bewerbung.
Die Fakultät Architektur und Landschaft bietet gemeinsam mit der École Nationale Supérieure d’Architecture de Strasbourg (ENSAS) ein Dt.-Frz. Doppeldiplom in Architektur an, das von der Dt.-Frz. Hochschule (DFH) gefördert wird. 50% der Studienleistungen des Hauptfachstudiums müssen dabei an der Partnerhochschule erbracht werden. Das Studium an der ENSAS findet im 7. und 8. Studiensemester statt; dort erbrachte Studien- und Prüfungsleistungen werden an der TU Dresden angerechnet. Zum Programm gehört auch ein mehrmonatiges Büropraktikum in Frankreich oder einem französischsprachigen Land.
Interessiert?
Auf der Webseite der Fakultät Architektur und Landschaft erhalten Sie detaillierte Informationen zum Deutsch-Französischen Doppeldiplom in Architektur, z. B. zu den Zielen des Studiengangs, zu Lehrveranstaltungen und Stundenplänen, aber auch zu Berufsperspektiven.
Bauingenieurwesen

© André Terpe

© André Terpe

© André Terpe
Bauingenieur:innen gestalten und bewahren den Lebensraum der Menschen. Dabei orientieren sich die Tätigkeits- und Forschungsschwerpunkte ganz besonders an den globalen Herausforderungen des 21. Jahrhunderts: Ressourcenknappheit, Klimawandel, Digitalisierung und Mobilität. Das Studium gliedert sich in Grund- und Hauptstudium über insgesamt 10 Semester. Ab dem 4. Semester wird dabei eine von sechs Vertiefungsrichtungen gewählt.
Interessiert?
Auf der Webseite der Fakultät Bauingenieurwesen erhalten Sie detaillierte Informationen zum Diplomstudiengang Bauingenieurwesen, z. B. zu den Zielen des Studiengangs, zu Lehrveranstaltungen und Stundenplänen, aber auch zu Berufsperspektiven.
Im zentralen Studieninformationssystem (SINS) finden Sie weitere wichtige Bedingungen zum Studiengang, wie z. B. Studienvoraussetzungen, die verbindlichen Bewerbungsfristen und den Link zur Bewerbung.
Für alle die bereits im Beruf stehen bietet sich ein Fernstudium an. Jedem Studierenden ist es mit individuellen Studienplänen möglich, das Studium in Abhängigkeit vom Vorwissen flexibel in Abfolge und Zeitumfang zu gestalten.
Interessiert?
Auf der Webseite der Fakultät Bauingenieurwesen erhalten Sie detaillierte Informationen zum Bachelorstudiengang Bauingenieurwesen (Fernstudium), z. B. zu den Zielen des Studiengangs, zu Lehrveranstaltungen und Stundenplänen, aber auch zu Berufsperspektiven.
Im zentralen Studieninformationssystem (SINS) finden Sie weitere wichtige Bedingungen zum Studiengang, wie z. B. Studienvoraussetzungen, die verbindlichen Bewerbungsfristen und den Link zur Bewerbung.
Für diejenigen, die einen ersten in Deutschland anerkannten berufsqualifizierenden Hochschulabschluss oder einen Abschluss einer staatlichen oder staatlich anerkannten Berufsakademie im Studiengang Bauingenieurwesen erlangt haben, ist ein Aufbaustudium gedacht. Die Regelstudiendauer hierfür beträgt 4 Semester einschließlich der Bearbeitungszeit für die Projekt- und Diplomarbeit. Das Aufbaustudium wird mit dem akademischen Grad Diplom-Ingenieur (Dipl.-Ing.) abgeschlossen.
Interessiert?
Auf der Webseite der Fakultät Bauingenieurwesen erhalten Sie detaillierte Informationen zum Aufbaustudiengang Wirtschaftsingenieurwesen (Diplom), z. B. zu den Zielen des Studiengangs, zu Lehrveranstaltungen und Stundenplänen, aber auch zu Berufsperspektiven.
Im zentralen Studieninformationssystem (SINS) finden Sie weitere wichtige Bedingungen zum Studiengang, wie z. B. Studienvoraussetzungen, die verbindlichen Bewerbungsfristen und den Link zur Bewerbung.
Die Fakultät Bauingenieurwesen führt für Personen, die einen ersten in Deutschland anerkannten berufsqualifizierenden Hochschulabschluss oder einen Abschluss einer staatlichen oder staatlich anerkannten Berufsakademie im Studiengang Bauingenieurwesen erlangt haben, ein Aufbaustudium durch. Die Regelstudiendauer hierfür beträgt m Teilzeit-Fernstudium acht Semester einschließlich der Bearbeitungszeit für die Projekt- und Diplomarbeit. Es gilt eine Zeitlimitierung, eine Mindestdauer ist jedoch nicht vorgeschrieben. Es ist mit etwa 20 Stunden pro Woche Selbststudium zu rechnen. Das Aufbaustudium wird mit dem akademischen Grad Diplom-Ingenieur (Dipl.-Ing.) abgeschlossen.
Interessiert?
Auf der Webseite der Fakultät Bauingenieurwesen erhalten Sie detaillierte Informationen zum Aufbaustudiengang Bauingenieurwesen (Diplom, Fernstudium), z. B. zu den Zielen des Studiengangs, zu Lehrveranstaltungen und Stundenplänen, aber auch zu Berufsperspektiven.
Im zentralen Studieninformationssystem (SINS) finden Sie weitere wichtige Bedingungen zum Studiengang, wie z. B. Studienvoraussetzungen, die verbindlichen Bewerbungsfristen und den Link zur Bewerbung.
Der englischsprachige Masterstudiengang ACCESS vermittelt fundierte Kenntnisse im Bereich innovativer computerunterstützter Methoden zu Modellierung, Entwurf, Analyse und Ertüchtigung von Strukturen im Bauingenieurwesen und richtet sich an Absolventen, die bereits einen Hochschulabschluss haben. Bewerber sollten bereits fundierte numerischen Fähigkeiten erworben haben.
Interessiert?
Auf der Webseite der Fakultät Bauingenieurwesen erhalten Sie detaillierte Informationen zum Masterstudiengang ACCESS, z. B. zu den Zielen des Studiengangs, zu Lehrveranstaltungen und Stundenplänen, aber auch zu Berufsperspektiven.
Im zentralen Studieninformationssystem (SINS) finden Sie weitere wichtige Bedingungen zum Studiengang, wie z. B. Studienvoraussetzungen, die verbindlichen Bewerbungsfristen und den Link zur Bewerbung.
Der Masterstudiengang Water Security and Global Change ist ein internationaler, englischsprachiger Studiengang, der die Themen der Wassersicherheit und des globalen Wandels umfasst. Der gemeinsame Masterstudiengang (Joint Degree) integriert die Expertise von drei Partnerhochschulen (RWTH Aachen, IIT Madras, TU Dresden) und wird in Zusammenarbeit mit zwei weiteren Partnern (UNU Flores und AIT Bangkok) entwickelt und durchgeführt. Der Studiengang fördert die Mobilität der Studierenden zwischen den drei Universitäten. Alle eingeschriebenen Studierenden beginnen das akademische Jahr am IIT Madras für etwa 8 Monate, gefolgt von 5 Monaten an der TU Dresden und abschließend 5 Monaten an der RWTH Aachen. Die Masterarbeit wird an einem der genannten Standorte über 5 Monate durchgeführt. Die Lehrveranstaltungen finden in der Regel in hybrider Form statt.
Der Masterstudiengang ist forschungsorientiert und legt inhaltliche Schwerpunkte auf die Planung, den Bau und den Betrieb von wasserwirtschaftlicher und wasserbaulicher Infrastruktur, insbesondere zur Adaption an klimawandelbedingte Extremereignisse im Binnen- und Küstenbereich. Zudem umfasst der Studiengang physiko-chemische, datenanalytische sowie hydrologische Grundlagen und die Modellierung komplexer Stoffströme in wasserbezogenen Systemen. Das Studium beinhaltet nationale und internationale Richtlinien und die Entwicklung wasserpolitischer und gesellschaftlicher Anforderungen. Weitere Inhalte des Studiums sind praxisorientierte Fallbeispiele sowie aktuelle Themen aus der Grundlagen- und anwendungsorientierten Forschung. Das Studium bietet eine Kombination aus theoretischen und methodisch-praktischen Grundlagen im Zusammenhang mit der Wassersicherheit im globalen Wandel.
Interessiert?
Weitere Informationen erhalten Sie hier: abcd-centre.org/master-program und demnächst auf der Webseite der Fakultät Bauingenieurwesen, z. B. zu den Zielen des Studiengangs, zu Lehrveranstaltungen und Stundenplänen, aber auch zu Berufsperspektiven.
Im zentralen Studieninformationssystem (SINS) finden Sie weitere wichtige Bedingungen zum Studiengang, wie z. B. Studienvoraussetzungen, die verbindlichen Bewerbungsfristen und den Link zur Bewerbung.
Umweltwissenschaften ─ Forstwissenschaften

© TUD

© TUD

© TUD
Die Ausbildung im Studiengang Forstwissenschaften befähigt die Absolventen zu einem Beruf mit vielfältigen Aufgaben und hoher Verantwortung: Erhaltung, Schutz, Pflege und Nutzung des Waldes, der als wichtigster Teil der natürlichen Umwelt den nachwachsenden Rohstoff Holz produziert, der Luftreinhaltung, dem Bodenschutz, dem Arten- und Biotopschutz, der Trinkwasserbereitstellung und in zunehmendem Maße der Erholung der Bevölkerung dient.
Interessiert?
Auf der Webseite der Fachrichtung Forstwissenschaften erhalten Sie detaillierte Informationen zum Bachelorstudiengang Forstwissenschaften, z. B. zu den Zielen des Studiengangs, zu Lehrveranstaltungen und Stundenplänen, aber auch zu Berufsperspektiven.
Im zentralen Studieninformationssystem (SINS) finden Sie weitere wichtige Bedingungen zum Studiengang, wie z. B. Studienvoraussetzungen, die verbindlichen Bewerbungsfristen und den Link zur Bewerbung.
Beim Masterstudiengang Forstwissenschaften steht der Wald mit all seinen Facetten im Mittelpunkt. In vielfältigen Modulen und den individuellen Interessen entsprechenden Vertiefungen können erworbene Grundlagenkenntnisse angewandt und weiter ausgebaut werden.
Ziel ist es, den Studierenden methodische Instrumentarien und ein an aktuellen Forschungsfragen orientiertes Fachwissen zu vermitteln.
Interessiert?
Auf der Webseite der Fachrichtung Forstwissenschaften erhalten Sie detaillierte Informationen zum Masterstudiengang Forstwissenschaften, z. B. zu den Zielen des Studiengangs, zu Lehrveranstaltungen und Stundenplänen, aber auch zu Berufsperspektiven.
Im zentralen Studieninformationssystem (SINS) finden Sie weitere wichtige Bedingungen zum Studiengang, wie z. B. Studienvoraussetzungen, die verbindlichen Bewerbungsfristen und den Link zur Bewerbung.
Der Masterstudiengang „Holztechnologie und Holzwirtschaft“ ist ein stärker anwendungsorientierter sowie ein interdisziplinärer Studiengang. Dieser wird gemeinsam von der Fakultät Umweltwissenschaften sowie von der Fakultät Maschinenwesen getragen. Den Studierenden werden die erforderlichen fachlichen Kenntnisse, Fähigkeiten und Methoden vermittelt, die sie zur kritischen Einordnung wissenschaftlicher Erkenntnisse und zum eigenverantwortlichen Handeln auf dem Gebiet der Holztechnologie und Holzwirtschaft befähigen.
Interessiert?
Auf der Webseite der Fachrichtung Forstwissenschaften erhalten Sie detaillierte Informationen zum Masterstudiengang Holztechnologie und Holzwirtschaft, z. B. zu den Zielen des Studiengangs, zu Lehrveranstaltungen und Stundenplänen, aber auch zu Berufsperspektiven.
Im zentralen Studieninformationssystem (SINS) finden Sie weitere wichtige Bedingungen zum Studiengang, wie z. B. Studienvoraussetzungen, die verbindlichen Bewerbungsfristen und den Link zur Bewerbung.
Der Studiengang dient der Ausbildung von Führungskräften zur Entwicklung wissensbasierter, innovativer und nachhaltiger Management-Konzepte für Naturwälder, Plantagenwälder und anderer Waldformationen sowie agroforstwirtschaftlicher Systeme und urbaner Grünräume einschließlich der Kontrolle ihrer Nutzung und Pflege.
Besonderes Augenmerk wird hierbei auf die flexible Anpassung an sich verändernde gesellschaftliche Bedingungen und die vielfältigen Interaktionen zwischen den Menschen und der Waldformationsentwicklung auf der Basis einer multidisziplinären Herangehensweise gelegt.
Interessiert?
Auf der Webseite der Fachrichtung Forstwissenschaften erhalten Sie detaillierte Informationen zum Masterstudiengang Tropical Forestry, z. B. zu den Zielen des Studiengangs, zu Lehrveranstaltungen und Stundenplänen, aber auch zu Berufsperspektiven.
Im zentralen Studieninformationssystem (SINS) finden Sie weitere wichtige Bedingungen zum Studiengang, wie z. B. Studienvoraussetzungen, die verbindlichen Bewerbungsfristen und den Link zur Bewerbung.
Umweltwissenschaften ─ Geowissenschaften

© Prof. Anna Cord

© Michael Kretzschmar

© Judith Miggelbrink
Geodäsie – das bedeutet, die Erde lokal, regional und global zu vermessen und abzubilden. Geodaten sind aus unserer heutigen Welt nicht mehr wegzudenken. Ob es um satellitengestützte Navigationssysteme, Vermessungsarbeiten auf Baustellen, die Überwachung komplexer Bauwerke, moderne Stadtplanung oder den Klimawandel geht – überall sind Geodät:innen bzw. Geoinformatiker:innen gefragt.
Interessiert?
Auf der Webseite der Fachrichtung Geowissenschaften erhalten Sie detaillierte Informationen zum Bachelorstudiengang Geodäsie und Geoinformation, z. B. zu den Zielen des Studiengangs, zu Lehrveranstaltungen und Stundenplänen, aber auch zu Berufsperspektiven.
Im zentralen Studieninformationssystem (SINS) finden Sie weitere wichtige Bedingungen zum Studiengang, wie z. B. Studienvoraussetzungen, die verbindlichen Bewerbungsfristen und den Link zur Bewerbung.
Geograph:innen befassen sich mit raumbezogenen Strukturen und Prozessen in Umwelt und Gesellschaft. Eine Besonderheit und Stärke der Geographie in Dresden liegt in der Verbindung natur- und gesellschaftswissenschaftlicher Inhalte in Forschung und Lehre. Ziel des Studiums ist die Befähigung zu integrativen und interdisziplinärem Arbeiten sowie fachspezifischer Methodik um die natürlichen Komponenten und Strukturen in der Landschaft sowie Gesellschaft-Raum-Verhältnisse zu verstehen.
Im zentralen Studieninformationssystem (SINS) finden Sie weitere wichtige Bedingungen zum Studiengang, wie z. B. Studienvoraussetzungen, die verbindlichen Bewerbungsfristen und den Link zur Bewerbung.
Im Studiengang Lehramt Geographie für Oberschule / Gymnasium stehen die fachwissenschaftlichen ebenso wie die fachdidaktischen Inhalte und Methoden theoretisch, forschungsorientiert sowie (bildungs- oder unterrichts-)praktisch im Zentrum. In einer zukunftsfähigen, geographischen Bildung werden komplexe und kontroverse Themen an der Schnittstelle zwischen Natur- und Gesellschaftswissenschaften multiperspektivisch aufgegriffen, reflektiert und in Lernanlässe überführt. Das Studium bietet für die Gestaltung solcher Lernanlässe fachliche und fachdidaktische Grundlagen und Vertiefungsmöglichkeiten, etwa in den Bereichen Bildung für nachhaltige Entwicklung, Digitalisierung oder außerschulisches Lernen.
Im zentralen Studieninformationssystem (SINS) finden Sie für Geographie an Oberschulen oder für Geographie an Gymnasien weitere wichtige Bedingungen zum Studiengang, wie z. B. Studienvoraussetzungen, die verbindlichen Bewerbungsfristen und den Link zur Bewerbung.
Cartography M.Sc. ist ein viersemestriges Master of Science-Programm, das in Kooperation zwischen der TU München, der TU Wien, der TU Dresden und der Universität Twente durchgeführt wird. Er konzentriert sich auf eine breite Ausbildung in Kartographie und Geoinformatik. Der Studiengang, der vollständig in englischer Sprache unterrichtet wird, beginnt jedes Jahr im Wintersemester.
Interessiert?
Auf der Webseite zum Studiengang erhalten Sie detaillierte Informationen zum Masterstudiengang Cartography, z. B. zu den Zielen des Studiengangs, zu Lehrveranstaltungen und Stundenplänen, aber auch zu Berufsperspektiven.
Im zentralen Studieninformationssystem (SINS) finden Sie weitere wichtige Bedingungen zum Studiengang, wie z. B. Studienvoraussetzungen, die verbindlichen Bewerbungsfristen und den Link zur Bewerbung.
Aufbauend auf dem breiten ingenieurmäßigen und geodätischen Grundlagenwissen aus einem vorangegangenen einschlägigen Bachelorstudium erlangen Studierende dieses Masterstudiengangs ein vertiefendes und stärker forschungsbezogenes Wissen in der Geodäsie und dessen Anwendungen. Die Masterausbildung ist wissenschaftlich und zugleich praktisch-berufsorientiert. Die Studierenden eignen sich methodische Kenntnisse und analytische Kompetenzen sowie ein an den aktuellen geodätischen Forschungsfragen und der geodätischen Praxis orientiertes Fachwissen an.
Interessiert?
Auf der Webseite der Fachrichtung Geowissenschaften erhalten Sie detaillierte Informationen zum Masterstudiengang Geodäsie, z. B. zu den Zielen des Studiengangs, zu Lehrveranstaltungen und Stundenplänen, aber auch zu Berufsperspektiven.
Im zentralen Studieninformationssystem (SINS) finden Sie weitere wichtige Bedingungen zum Studiengang, wie z. B. Studienvoraussetzungen, die verbindlichen Bewerbungsfristen und den Link zur Bewerbung.
Die Geoinformatik bildet die wissenschaftliche Grundlage für Navigationssysteme, Geoinformationssysteme, Geodateninfrastrukturen und andere Systeme zur räumlichen Entscheidungsunterstützung und Planung. Sie liefert die technologische Basis für die Verbesserung des Systemverständnisses und zur Beantwortung von raumbezogenen Fragen zu aktuellen Themen wie dem Klimawandel und dem nachhaltigen Management natürlicher Ressourcen auf lokaler, regionaler und globaler Ebene. Studierende erwerben im Rahmen des Masterstudienganges Geoinformatics Kompetenzen in der Entwicklung und Handhabung wissenschaftlicher und technologischer Methoden der Geoinformatik. Die Geoinformatik ist ein Teilgebiet der angewandten Informatik, in dem die Berücksichtigung des räumlichen Bezuges von Daten und die Beantwortung räumlicher Fragestellungen zentral sind. Ziel ist die Entwicklung und Anwendung informatorischer Methoden zur Lösung fachspezifischer Probleme in den Geo-, Forst- und Hydrowissenschaften, in der Landschafts-, Umwelt- und Infrastrukturplanung, der Umweltmedizin sowie in weiteren verwandten Disziplinen.
Im zentralen Studieninformationssystem (SINS) finden Sie weitere wichtige Bedingungen zum Studiengang, wie z. B. Studienvoraussetzungen, die verbindlichen Bewerbungsfristen und den Link zur Bewerbung.
Raumentwicklung und Naturressourcenmanagement ist ein interdisziplinärer und forschungsorientierter Masterstudiengang mit hohem Anwendungsbezug. Im Mittelpunkt des viersemestrigen Studiums stehen die aktuellen Herausforderungen für unsere Gesellschaft an der Schnittstelle von Umweltwissenschaften und Raumplanung. Durch die umfangreiche und gleichberechtigte Verknüpfung von Lehrangeboten aller drei Fachrichtungen der Fakultät Umweltwissenschaften (Forst-, Geo- und Hydrowissenschaften), weiterer Fakultäten der TU Dresden sowie führender außeruniversitärer Einrichtungen, insbesondere des Leibniz-Instituts für ökologische Raumentwicklung, wird eine Vielzahl von Möglichkeiten geschaffen, jenseits eines fixierten Kernbereichs individuelle Vertiefungen und Spezialisierungen zu entwickeln.
Interessiert?
Auf der Webseite der Fakultät Umweltwissenschaften erhalten Sie detaillierte Informationen zum Masterstudiengang Raumentwicklung und Naturressourcenmanagement, z. B. zu den Zielen des Studiengangs, zu Lehrveranstaltungen und Stundenplänen, aber auch zu Berufsperspektiven.
Im zentralen Studieninformationssystem (SINS) finden Sie weitere wichtige Bedingungen zum Studiengang, wie z. B. Studienvoraussetzungen, die verbindlichen Bewerbungsfristen und den Link zur Bewerbung.
Die Bewältigung globaler Umweltprobleme wie Klimawandel, Artenverlust und Ressourcenknappheit und deren Auswirkungen auf Wirtschaft und Gesellschaft erfordert innovative Lösungen. Die Informatik spielt dabei eine Schlüsselrolle – von Umweltüberwachung, Frühwarnsystemen, künstlicher Intelligenz bis hin zu nachhaltigen Technologien. Der Bachelorstudiengang Umweltinformatik an der TU Dresden verknüpft Umweltwissenschaften mit Informatik und kombiniert damit Klima- und Ökologiefragen mit Big Data, Datenanalyse und Künstlicher Intelligenz. Getragen durch die Fakultät Umweltwissenschaften in Kooperation mit der Fakultät Informatik, umfasst das Studium Inhalte aus Geo-, Hydro- und Forstwissenschaften sowie der Angewandten Informatik. Absolvent:innen erwerben fundierte Kenntnisse in Umweltprozessen, Programmierung, Datenanalyse, Statistik und maschinellem Lernen und sind qualifiziert für Tätigkeiten in Umweltmonitoring, -planung und Datenanalyse in Behörden und Unternehmen.
Der Studiengang Umweltinformatik bietet eine interdisziplinäre Ausbildung, da neben Modulen aus den Umweltwissenschaften eine enge Zusammenarbeit mit der Fakultät Informatik gefördert wird. Absolvent:innen werden somit optimal auf Berufsfelder im Bereich Umweltmonitoring und -datenanalyse vorbereitet und qualifizieren sich zu Experten an der Schnittstelle zwischen IT, Big Data, künstlicher Intelligenz, maschinellem Lernen, Erdbeobachtung, globalem Wandel und Nachhaltigkeit.
Interessiert?
Auf der Webseite der Fachrichtung Geowissenschaften erhalten Sie detaillierte Informationen zum Bachelorstudiengang Umweltinformatik, z. B. zu den Zielen des Studiengangs, zu Lehrveranstaltungen und Stundenplänen, aber auch zu Berufsperspektiven.
Im zentralen Studieninformationssystem (SINS) finden Sie weitere wichtige Bedingungen zum Studiengang, wie z. B. Studienvoraussetzungen, die verbindlichen Bewerbungsfristen und den Link zur Bewerbung.
Umweltwissenschaften ─ Hydrowissenschaften

© Institut für Hydrologie und Meteorologie

© Institut für Hydrologie und Meteorologie

© Institut für Siedlungs- und Industriewasserwirtschaft
Die Erforschung, Gewinnung, Verteilung und Reinigung von Wasser als Lebensmittel und Ressource ist eine der grundlegendsten technischen und sozialen Errungenschaften. Das Studium der Hydrowissenschaften vermittelt Ihnen das naturwissenschaftliche und ingenieurtechnische Wissen und die praktischen Kompetenzen, um in diesem Bereich tätig zu sein. Dazu gehören die Quantifizierung physikalischer, chemischer und biologischer Komponenten in Hydrosystemen sowie die ingenieurwissenschaftlich-technische Beherrschung von Wassergewinnung, Wassernutzung, Wasseraufbereitung und Abwasserbehandlung unter Berücksichtigung von Randbedingungen der Gesellschaft und Ökonomie - insbesondere vor dem Hintergrund des Klimawandels.
Interessiert?
Auf der Webseite der Fachrichtung Hydrowissenschaften erhalten Sie detaillierte Informationen zum Bachelorstudiengang Hydrowissenschaften, z. B. zu den Zielen des Studiengangs, zu Lehrveranstaltungen und Stundenplänen, aber auch zu Berufsperspektiven.
Im zentralen Studieninformationssystem (SINS) finden Sie weitere wichtige Bedingungen zum Studiengang, wie z. B. Studienvoraussetzungen, die verbindlichen Bewerbungsfristen und den Link zur Bewerbung.
Wasser ist die Grundlage allen Lebens. Es ist überall auf der Erde zu finden und immer in Bewegung. Das globale Bevölkerungswachstum, Umweltzerstörung, Klimawandel und Wetterextreme sowie Verunreinigungen wirken sich jedoch weltweit zunehmend negativ auf die regionale Verfügbarkeit und Qualität der Ressource Wasser aus. Um diesen nachteiligen Einflüssen zu begegnen, lernen Studierende im Studiengang Hydrologie die Entwicklung und den fachgerechten Einsatz anwendungsorientierter, innovativer Lösungsstrategien zur nachhaltigen Bewirtschaftung natürlicher Wasserressourcen und für den Umgang mit Extremereignissen wie Hochwasser und Trockenheit.
Interessiert?
Auf der Webseite der Fachrichtung Hydrowissenschaften erhalten Sie detaillierte Informationen zum Masterstudiengang Hydrologie, z. B. zu den Zielen des Studiengangs, zu Lehrveranstaltungen und Stundenplänen, aber auch zu Berufsperspektiven.
Im zentralen Studieninformationssystem (SINS) finden Sie weitere wichtige Bedingungen zum Studiengang, wie z. B. Studienvoraussetzungen, die verbindlichen Bewerbungsfristen und den Link zur Bewerbung.
Die Hydrobiologie befasst sich mit in Gewässern lebenden Organismen und mit den Wechselbeziehungen der Organismen untereinander und zu ihrer Umwelt. Hydrobiologen beobachten, analysieren und modellieren Prozesse in allen Formen belebter aquatischer Systeme: in Seen und Talsperren, im Grundwasser, in Bächen und Flüssen, sowie in Kläranlagen.
Interessiert?
Auf der Webseite der Fachrichtung Hydrowissenschaften erhalten Sie detaillierte Informationen zum Masterstudiengang Hydrobiologie, z. B. zu den Zielen des Studiengangs, zu Lehrveranstaltungen und Stundenplänen, aber auch zu Berufsperspektiven.
Im zentralen Studieninformationssystem (SINS) finden Sie weitere wichtige Bedingungen zum Studiengang, wie z. B. Studienvoraussetzungen, die verbindlichen Bewerbungsfristen und den Link zur Bewerbung.
Hydro Science and Engineering (HSE) is a full-time international two-year master course combining all fields of water management from engineering, natural and environmental sciences. In Dresden, Water Sciences and Hydro Engineering and the cooperation between scientists and engineers have a long tradition (e.g., the first large modern waste-water plant from 1912). Students can be supported by stipends, e.g., via the DAAD EPOS Programme.
Interested?
On the website of the Department of Hydro Sciences you can find detailed information on the master's program Hydro Science and Engineering, e.g. on the objectives of the programme, on courses and timetables but also on career prospects.
In our central study information system (SINS) you can find further important conditions for the degree programme, such as study requirements, the binding application deadlines and the link to the application.
Im Masterstudiengang Kreislaufwirtschaft und Ressourceneffizienz erlernen die Studierenden den nachhaltigen Umgang mit (sekundären) Rohstoffen und Ressourcen sowie Technologien zur Umweltreinhaltung und des Klimaschutzes. Es werden Umweltingenieure ausgebildet, die Konzepte und Technologien in der Abfall- und Kreislaufwirtschaft und der Altlastenbehandlung anwenden können und somit zur Transformation in Richtung nachhaltige Gesellschaft entsprechend des Europäischen Abkommens „Green Deal“ beitragen.
Interessiert?
Auf der Webseite der Fachrichtung Hydrowissenschaften erhalten Sie detaillierte Informationen zum Masterstudiengang Kreislaufwirtschaft und Ressourceneffizienz, z. B. zu den Zielen des Studiengangs, zu Lehrveranstaltungen und Stundenplänen, aber auch zu Berufsperspektiven.
Im zentralen Studieninformationssystem (SINS) finden Sie weitere wichtige Bedingungen zum Studiengang, wie z. B. Studienvoraussetzungen, die verbindlichen Bewerbungsfristen und den Link zur Bewerbung.
Die Wasserwirtschaft stellt sich den Anforderungen aus der immer zwingender werdenden Mehrfach- und Kreislaufnutzung des Wassers und seiner Inhaltsstoffe durch Erforschung der für die unterschiedlichsten Nutzungen benötigten Wassermengen und -qualitäten. Dies beinhaltet naturwissenschaftliche, verfahrenstechnische und bautechnische Entwicklungsaufgaben unter Beachtung der natürlichen Umweltbedingungen. Die Wasserwirtschaft ist in wesentlichem Maß für die vitale Entwicklung von Bevölkerung, Industrie und Landwirtschaft verantwortlich. Voraussetzungen für die daraus erwachsenden Aufgaben sind die ingenieurwissenschaftliche und technische Beherrschung der Bewirtschaftung ober- und unterirdischer Gewässer, der Trink- und Prozesswasseraufbereitung, der wasserwirtschaftlichen Ver- und Entsorgungsnetze, der Siedlungshydrologie sowie der kommunalen und industriellen Abwasserbehandlung.
Interessiert?
Auf der Webseite der Fachrichtung Hydrowissenschaften erhalten Sie detaillierte Informationen zum Masterstudiengang Wasserwirtschaft, z. B. zu den Zielen des Studiengangs, zu Lehrveranstaltungen und Stundenplänen, aber auch zu Berufsperspektiven.
Im zentralen Studieninformationssystem (SINS) finden Sie weitere wichtige Bedingungen zum Studiengang, wie z. B. Studienvoraussetzungen, die verbindlichen Bewerbungsfristen und den Link zur Bewerbung.
The programme offers a distinctive curriculum built on the cornerstones of hydrogeology, hydrology and climatology. With this curriculum GroundwatCH aims to increase the knowledge and skills regarding the interactions between groundwater, surface water, climate and global change, as well as the need to consider and benefit from these interactions when dealing with adaptation.
The Erasmus+ (Erasmus Mundus) Joint Master Program is offered by an international consortium consisting of:
Interested?
On the website of the Department of Hydro Sciences you can find detailed information on the Erasmus Mundus master´s program Groundwater and Global Change - Impacts and Adaptation, and also on the Erasmus Mundus website of this program, e.g. on the objectives and timetables but also on career prospects.
In our central study information system (SINS) you can find further important conditions for the degree programme, such as study requirements, the binding application deadlines and the link to the application.
Verkehrswissenschaften

© Benjamin Jenak, TUD

© Benjamin Jenak, TUD

© Benjamin Jenak, TUD
Mobilität und Verkehr sind heute und in Zukunft grundlegende Bestandteile der Gesellschaft, unverzichtbar für Handel und Wirtschaft und daher von großer Bedeutung. Der Studiengang vermittelt übergreifende verkehrswissenschaftliche Kompetenzen, Inhalte und Methoden aus den Natur- und Ingenieurwissenschaften, den Umwelt- sowie den Wirtschaftswissenschaften, der Psychologie und den Sozialwissenschaften, jeweils mit Bezug auf Verkehrs- und Mobilitätsthemen.
Interessiert?
Auf der Webseite der Fakultät Verkehrswissenschaften erhalten Sie detaillierte Informationen zum Bachelorstudiengang Mobilität und Verkehrssysteme, z. B. zu den Zielen des Studiengangs, zu Lehrveranstaltungen und Stundenplänen, aber auch zu Berufsperspektiven.
Im zentralen Studieninformationssystem (SINS) finden Sie weitere wichtige Bedingungen zum Studiengang, wie z. B. Studienvoraussetzungen, die verbindlichen Bewerbungsfristen und den Link zur Bewerbung.
Trotz knapper werdender Ressourcen und Klimaschutzbestrebungen ist es notwendig, allen Menschen Mobilität zu möglichst geringen Kosten zu ermöglichen. Im Zentrum des Studiengangs stehen betriebs- und volkswirtschaftliche Kenntnisse zur Bearbeitung und Lösung verkehrswissenschaftlicher Fragestellungen. Die Studierenden werden befähigt, Entscheidungen auf wirtschaftlichen, politischen und gesellschaftlichen Ebenen zu treffen.
Interessiert?
Auf der Webseite der Fakultät Verkehrswissenschaften erhalten Sie detaillierte Informationen zum Bachelorstudiengang Verkehrswirtschaft, z. B. zu den Zielen des Studiengangs, zu Lehrveranstaltungen und Stundenplänen, aber auch zu Berufsperspektiven.
Im zentralen Studieninformationssystem (SINS) finden Sie weitere wichtige Bedingungen zum Studiengang, wie z. B. Studienvoraussetzungen, die verbindlichen Bewerbungsfristen und den Link zur Bewerbung.
Durch die wachsende Globalisierung hat der Luftverkehr einen hohen Stellenwert in der Personenbeförderung und im Gütertransport. Der Studiengang verbindet die betrieblichen und planerischen Aspekte des Luftverkehrs mit den Fächern der Logistik und Verkehrssystemtheorie. Die Studierenden erwerben in Theorie und Praxis ein vielfältiges technisches, operatives, logistisches, wirtschaftliches und juristisches Know-how. Damit sind sie auf die heutigen Anforderungen und die zukünftigen Herausforderungen in der Luftfahrtindustrie vorbereitet und für vielfältige Karrieremöglichkeiten qualifiziert.
Interessiert?
Auf der Webseite der Fakultät Verkehrswissenschaften erhalten Sie detaillierte Informationen zum Masterstudiengang Air Transport and Logistics, z. B. zu den Zielen des Studiengangs, zu Lehrveranstaltungen und Stundenplänen, aber auch zu Berufsperspektiven.
Im zentralen Studieninformationssystem (SINS) finden Sie weitere wichtige Bedingungen zum Studiengang, wie z. B. Studienvoraussetzungen, die verbindlichen Bewerbungsfristen und den Link zur Bewerbung.
Durch die Bestrebung, mehr Verkehr auf die Schiene zu verlagern, ist die Nachfrage nach Ingenieur:innen im Eisenbahnwesen sehr groß. Studierende erhalten alle notwendigen ingenieurwissenschaftlichen und verkehrswissenschaftlichen Kenntnisse, um das System Eisenbahn in seiner Komplexität zu verstehen und für die Zukunft gestalten zu können. So beinhaltet das Masterstudium alle Facetten des Eisenbahnwesens, von den Themen Infrastruktur und Bahnbau über Sicherungstechnik und Telematik bis hin zu Bahnbetrieb und ÖPNV.
Interessiert?
Auf der Webseite der Fakultät Verkehrswissenschaften erhalten Sie detaillierte Informationen zum Masterstudiengang Bahnsystemingenieurwesen, z. B. zu den Zielen des Studiengangs, zu Lehrveranstaltungen und Stundenplänen, aber auch zu Berufsperspektiven.
Im zentralen Studieninformationssystem (SINS) finden Sie weitere wichtige Bedingungen zum Studiengang, wie z. B. Studienvoraussetzungen, die verbindlichen Bewerbungsfristen und den Link zur Bewerbung.
Durch die Verlagerung von konventionellen zu elektrischen Antrieben werden Ingenieur:innen im Bereich Elektrischer Verkehrssysteme weltweit gesucht. Der Studiengang enthält verkehrsträgerübergreifende Kenntnisse zum Aufbau, der Funktionsweise und den Anwendungsgebieten elektrisch betriebener Verkehrssysteme. Die Teilsysteme Energieversorgung und Fahrzeug werden genauso beleuchtet wie die Besonderheiten und Herausforderungen der mobilen Anwendung. Neben allgemein-ingenieurwissenschaftliche Methoden werden vor allem Inhalte des elektrisch betriebenen Verkehrs sowie des Managements von Projekten und Verkehrsunternehmen vermittelt.
Interessiert?
Auf der Webseite der Fakultät Verkehrswissenschaften erhalten Sie detaillierte Informationen zum Masterstudiengang Elektrische Verkehrssystem, z. B. zu den Zielen des Studiengangs, zu Lehrveranstaltungen und Stundenplänen, aber auch zu Berufsperspektiven.
Im zentralen Studieninformationssystem (SINS) finden Sie weitere wichtige Bedingungen zum Studiengang, wie z. B. Studienvoraussetzungen, die verbindlichen Bewerbungsfristen und den Link zur Bewerbung.
Die Verkehrsbranche benötigt Expert:innen, die mit Hilfe analytischer Methoden, Datenanalyse sowie Programmierung und Modellierung zukunftsweisende Entscheidungen vorbereiten und treffen können. Dazu befähigt der auf grundlegende Kenntnisse der Volks- und Betriebswirtschaftslehre sowie quantitativer Verfahren (Mathematik, Statistik, Ökonometrie) aufbauende Studiengang. Er kombiniert Verkehrswissen mit wirtschaftswissenschaftlichen Methoden.
Interessiert?
Auf der Webseite der Fakultät Verkehrswissenschaften erhalten Sie detaillierte Informationen zum Masterstudiengang Transportation Economics and Data Science , z. B. zu den Zielen des Studiengangs, zu Lehrveranstaltungen und Stundenplänen, aber auch zu Berufsperspektiven.
Im zentralen Studieninformationssystem (SINS) finden Sie weitere wichtige Bedingungen zum Studiengang, wie z. B. Studienvoraussetzungen, die verbindlichen Bewerbungsfristen und den Link zur Bewerbung.
Verkehrssysteme der Zukunft planen - datenbasiert und nachhaltig: Der Master-Studiengang vermittelt vertiefte Kenntnisse zur Erhebung und Analyse von Daten zu Mobilitätsverhalten. Im Studium wird das Mobilitätsverhalten von Verkehrsteilnehmenden modelliert und dessen Auswirkungen auf Gesellschaft, Wirtschaft und Umwelt untersucht. Darüber hinaus werden Methoden der Mobilitätsplanung, insbesondere mit Blick auf umweltfreundliche und innovative Mobilitätsangebote, gelehrt.
Interessiert?
Auf der Webseite der Fakultät Verkehrswissenschaften erhalten Sie detaillierte Informationen zum englischsprachigen Masterstudiengang Mobility Systems , z. B. zu den Zielen des Studiengangs, zu Lehrveranstaltungen und Stundenplänen, aber auch zu Berufsperspektiven.
Im zentralen Studieninformationssystem (SINS) finden Sie weitere wichtige Bedingungen zum Studiengang, wie z. B. Studienvoraussetzungen, die verbindlichen Bewerbungsfristen und den Link zur Bewerbung.
Wirtschaftswissenschaften

© Klaus Gigga

© Klaus Gigga

© Klaus Gigga
Der Diplomstudiengang Wirtschaftsingenieurwesen zeichnet sich durch seine interdisziplinäre Ausrichtung aus. Sie erwerben breites Wissen in Wirtschafts- und Ingenieurwissenschaften und Methoden, mit denen Sie ineinandergreifende technische und wirtschaftliche Fragestellungen überblicken und Probleme an der Schnittstelle von Wirtschaft, Naturwissenschaft und Technik lösen können. Dabei können Sie sich fachlich entsprechend Ihrer individuellen Interessen in einer Weise spezialisieren, die ihresgleichen sucht.
Interessiert?
Auf der Webseite der Fakultät Wirtschaftswissenschaften erhalten Sie detaillierte Informationen zum Diplomstudiengang Wirtschaftsingenieurwesen, z. B. zu den Zielen des Studiengangs, zu Lehrveranstaltungen und Stundenplänen, aber auch zu Berufsperspektiven.
Im zentralen Studieninformationssystem (SINS) finden Sie weitere wichtige Bedingungen zum Studiengang, wie z. B. Studienvoraussetzungen, die verbindlichen Bewerbungsfristen und den Link zur Bewerbung.
In der Wirtschaftsinformatik beschäftigen Sie sich damit, wie Informations- und Kommunikationssysteme in Wirtschaft und Verwaltung gestaltet und eingesetzt werden. In diesem Studium an der Schnittstelle von Wirtschaft und Informationstechnik erwerben Sie zunächst eine breite Grundlagenausbildung in Betriebs- und Volkswirtschaftslehre, Wirtschaftsinformatik, Informatik und Methoden. Darauf aufbauend vertiefen Sie in einem breit angelegten Wahlpflichtbereich ihre individuellen Interessensschwerpunkte. So werden Sie in die Lage versetzt, fachübergreifende Probleme zu erkennen und entsprechende Lösungen zu entwickeln.
Interessiert?
Auf der Webseite der Fakultät Wirtschaftswissenschaften erhalten Sie detaillierte Informationen zum Diplomstudiengang Wirtschaftsinformatik, z. B. zu den Zielen des Studiengangs, zu Lehrveranstaltungen und Stundenplänen, aber auch zu Berufsperspektiven.
Im zentralen Studieninformationssystem (SINS) finden Sie weitere wichtige Bedingungen zum Studiengang, wie z. B. Studienvoraussetzungen, die verbindlichen Bewerbungsfristen und den Link zur Bewerbung.
Im Bachelor Wirtschaftswissenschaften lernen Sie die Grundlagen ökonomischer Analyse und wirtschaftlichen Denkens kennen. Sie erhalten Einblicke in fundamentale betriebs- und volkswirtschaftliche Themen und Problemstellungen und erwerben die für deren Analyse nötigen methodischen Kenntnisse. Hierauf aufbauend können Sie sich in vielfältiger Weise spezialisieren und ganz nach Ihren Interessen wirtschaftlichen Fragen auf den Grund gehen – aus der Betriebswirtschaftslehre, der Volkswirtschaftslehre, beiden Fächern oder auch weiteren, verwandten Disziplinen.
Interessiert?
Auf der Webseite der Fakultät Wirtschaftswissenschaften erhalten Sie detaillierte Informationen zum Bachelorstudiengang Wirtschaftswissenschaften, z. B. zu den Zielen des Studiengangs, zu Lehrveranstaltungen und Stundenplänen, aber auch zu Berufsperspektiven.
Im zentralen Studieninformationssystem (SINS) finden Sie weitere wichtige Bedingungen zum Studiengang, wie z. B. Studienvoraussetzungen, die verbindlichen Bewerbungsfristen und den Link zur Bewerbung.
Im Bachelor Wirtschaftspädagogik beschäftigen Sie sich damit, wie man wirtschaftswissenschaftliche Inhalte nachhaltig an verschiedene Zielgruppen vermittelt. Neben den Wirtschaftswissenschaften geht es hier auch um Erziehungswissenschaften und Psychologie, damit Sie wirtschaftswissenschaftliche und -pädagogische Probleme erkennen und wissenschaftlich analysieren können. Dabei stehen zwei Studienrichtungen zur Verfügung: Während Studienrichtung I stärker wirtschaftswissenschaftlich ausgerichtet ist, beinhaltet die Studienrichtung II eine allgemeinbildende Qualifizierungsrichtung, die Sie für eine spätere Lehrtätigkeit vorbereitet.
Interessiert?
Auf der Webseite der Fakultät Wirtschaftswissenschaften erhalten Sie detaillierte Informationen zum Bachelorstudiengang Wirtschaftspädagogik, z. B. zu den Zielen des Studiengangs, zu Lehrveranstaltungen und Stundenplänen, aber auch zu Berufsperspektiven.
Im zentralen Studieninformationssystem (SINS) finden Sie weitere wichtige Bedingungen zum Studiengang, wie z. B. Studienvoraussetzungen, die verbindlichen Bewerbungsfristen und den Link zur Bewerbung.
Im Masterstudiengang Betriebswirtschaftslehre erhalten Sie eine fundierte forschungsorientierte Managementausbildung. Sie erlernen die methodischen und fachlichen Kenntnisse, komplexe betriebswirtschaftliche Probleme zu analysieren und Lösungsvorschläge zu erarbeiten. Dabei steht Ihnen eine Fülle an betriebswirtschaftlichen Themengebieten zur Verfügung, in die Sie sich ganz nach Ihrer eigenen Interessenlage vertiefen können.
Interessiert?
Auf der Webseite der Fakultät Wirtschaftswissenschaften erhalten Sie detaillierte Informationen zum Masterstudiengang Betriebswirtschaftslehre, z. B. zu den Zielen des Studiengangs, zu Lehrveranstaltungen und Stundenplänen, aber auch zu Berufsperspektiven.
Im zentralen Studieninformationssystem (SINS) finden Sie weitere wichtige Bedingungen zum Studiengang, wie z. B. Studienvoraussetzungen, die verbindlichen Bewerbungsfristen und den Link zur Bewerbung.
Der Masterstudiengang Wirtschaftspädagogik beschäftigt sich aus interdisziplinärer Perspektive mit der Frage, wie wirtschaftswissenschaftliche Inhalte unterschiedlichen Zielgruppen vermittelt werden können. Das Studium ist so aufgebaut, dass Sie eigene Interessensgebiete durch eine Spezialisierung in einzelnen Bereichen der Wirtschaftswissenschaften und anderer Disziplinen vertiefen können. Dazu gehört auch, dass Sie die Wahl zwischen der vertiefend wirtschaftswissenschaftlich ausgerichteten Studienrichtung I und der auf den Schuldienst vorbereitenden Studienrichtung II haben.
Interessiert?
Auf der Webseite der Fakultät Wirtschaftswissenschaften erhalten Sie detaillierte Informationen zum Masterstudiengang Wirtschaftspädagogik, z. B. zu den Zielen des Studiengangs, zu Lehrveranstaltungen und Stundenplänen, aber auch zu Berufsperspektiven.
Im zentralen Studieninformationssystem (SINS) finden Sie weitere wichtige Bedingungen zum Studiengang, wie z. B. Studienvoraussetzungen, die verbindlichen Bewerbungsfristen und den Link zur Bewerbung.
Im Masterstudiengang Public and International Economics beschäftigen Sie sich mit drängenden wirtschaftlichen Herausforderungen unserer Zeit. Die meisten von ihnen, wie Klimawandel, Finanzkrisen, Störungen auf den Rohstoffmärkten und Einkommensunterschiede, sind länderübergreifender Natur. Sie anzugehen, erfordert ein fundiertes Verständnis wirtschaftspolitischer Maßnahmen auf nationaler wie internationaler Ebene samt ihren Verflechtungen und der Möglichkeiten und Grenzen transnationaler Kooperation. Genau dies lernen Sie in diesem Studiengang und können wirtschaftspolitische Probleme in einer globalisierten Welt mit modernen empirischen und theoretischen Methoden analysieren und Lösungsvorschläge erarbeiten.
Interessiert?
Auf der Webseite der Fakultät Wirtschaftswissenschaften erhalten Sie detaillierte Informationen zum Masterstudiengang Public and International Economics, z. B. zu den Zielen des Studiengangs, zu Lehrveranstaltungen und Stundenplänen, aber auch zu Berufsperspektiven.
Im zentralen Studieninformationssystem (SINS) finden Sie weitere wichtige Bedingungen zum Studiengang, wie z. B. Studienvoraussetzungen, die verbindlichen Bewerbungsfristen und den Link zur Bewerbung.
Internationales Hochschulinstitut (IHI Zittau)

© TUD, Amac Garbe

© TUD, Amac Garbe

© TUD, Amac Garbe
Der kooperativen Masterstudiengang mit der Hochschule Zittau/Görlitz wird mit den Spezialisierungen "Biotechnologie" sowie "Biodiversität und Naturschutz" angeboten. Ziel ist es, Fachleute für den internationalen Einsatz auf den Gebieten der biotechnologischen Forschung und Produktion, der Umweltvorsorge und -nachsorge sowie Biodiversitätsforschung und Naturschutz auszubilden. Dabei liegt der Fokus auf Grundlagen in den Bereichen praktische Mikrobiologie und Biotechnologie sowie Ökologie und Ökosystemkunde. Lehrsprachen sind Deutsch und Englisch.
Interessiert?
Auf der Webseite des internationalen Hochschulinstituts Zittau (IHI) erhalten Sie detaillierte Informationen zum Masterstudiengang Biotechnologie und Angewandte Ökologie, z. B. zu den Zielen des Studiengangs, zu Lehrveranstaltungen und Stundenplänen, aber auch zu Berufsperspektiven.
Im zentralen Studieninformationssystem (SINS) finden Sie weitere wichtige Bedingungen zum Studiengang, wie z. B. Studienvoraussetzungen, die verbindlichen Bewerbungsfristen und den Link zur Bewerbung.
Der englischsprachige, in der Studierendschaft hoch internationale Masterstudiengang vermittelt Wissen und Methoden zur Analyse drängender Umweltprobleme und zur Entwicklung gesellschaftlich relevanter Lösungsansätze. Ein Schwerpunkt liegt dabei auf inter- und transdisziplinären Ansätzen aus den Natur- und Sozialwissenschaften für den Schutz und die nachhaltige Nutzung der Biodiversität und die Bereitstellung von Ökosystemleistungen für gegenwärtige und zukünftige Generationen. Dabei können Lehrangebote der Fakultät Umweltwissenschaften sowie des Senckenberg Museum für Naturkunde Görlitz mitgenutzt werden.
Interessiert?
Auf der Webseite des internationalen Hochschulinstituts Zittau (IHI) erhalten Sie detaillierte Informationen zum Masterstudiengang Ecosystem Services, z. B. zu den Zielen des Studiengangs, zu Lehrveranstaltungen und Stundenplänen, aber auch zu Berufsperspektiven.
Im zentralen Studieninformationssystem (SINS) finden Sie weitere wichtige Bedingungen zum Studiengang, wie z. B. Studienvoraussetzungen, die verbindlichen Bewerbungsfristen und den Link zur Bewerbung.
Dieser kooperativ mit der Hochschule Zittau/Görlitz angebotene Studiengang vermittelt neben den klassischen betriebswirtschaftlichen und managementbezogenen Fachkenntnissen vor allem die Besonderheiten internationaler Unternehmenstätigkeit, Fremdsprachenkenntnisse und interkulturelle Kompetenzen. Ein Double Degree kann über Aufenthalte an unseren Partnerhochschulen in Mittel-/Osteuropa erworben werden, insbesondere durch modulgenaue Wahl an der nahen TU Liberec. Lehrsprachen sind Englisch und Deutsch.
Interessiert?
Auf der Webseite des internationalen Hochschulinstituts Zittau (IHI) erhalten Sie detaillierte Informationen zum Masterstudiengang Internationales Management, z. B. zu den Zielen des Studiengangs, zu Lehrveranstaltungen und Stundenplänen, aber auch zu Berufsperspektiven.
Im zentralen Studieninformationssystem (SINS) finden Sie weitere wichtige Bedingungen zum Studiengang, wie z. B. Studienvoraussetzungen, die verbindlichen Bewerbungsfristen und den Link zur Bewerbung.
Bei diesem gemeinsam mit der Fakultät Biologie und dem Senckenberg Museum für Naturkunde in Görlitz durchgeführten englischsprachigen Studiengang erwerben die Studierenden in drei Vertiefungsrichtungen Species Diversity and Natural History Collections, Evolution of Functional Biodiversity und Molecular Biodiversity Kenntnisse zur Evolution der Artenvielfalt und ihrer Dokumentation in Sammlungen sowie zu molekularbiologischen Ansätzen. Dabei stehen moderne organismische oder molekulare Methoden der Biodiversitätsforschung im Fokus und werden im Rahmen eigener Studierendenprojekte vertieft.
Interessiert?
Auf der Webseite des internationalen Hochschulinstituts Zittau (IHI) erhalten Sie detaillierte Informationen zum Masterstudiengang Organismic and Molecular Biodiversity, z. B. zu den Zielen des Studiengangs, zu Lehrveranstaltungen und Stundenplänen, aber auch zu Berufsperspektiven.
Im zentralen Studieninformationssystem (SINS) finden Sie weitere wichtige Bedingungen zum Studiengang, wie z. B. Studienvoraussetzungen, die verbindlichen Bewerbungsfristen und den Link zur Bewerbung.
Zentrale Beratungsangebote der TU Dresden
- ServiceCenterStudium (Fragen zu Bewerbung, Immatrikulation, rund um das Studium)
- Zentrale Studienberatung (Fragen zur Studienwahl)
- International Office (Beratung für internationale Bewerber:innen)
- Campusbüro (Beratung zur Vereinbarkeit von Studium / Beruf und Familie, Studieren mit Kind)
- Studentenwerk (Beratung zu Wohnheimen, zur Studienfinanzierung, Überblick und Speisepläne der Mensen)
- Interessengemeinschaft Studium und Behinderung (IGB) (Fragen zum Studium mit gesundheitlicher Beeinträchtigung)
- StuRa – Studierendenrat (Beratung von Studenten für Studenten)
- Career Service (Beratung zum Berufseinstieg)
- Psychosoziale Beratungsstelle
- Mutterschutz
- Beschwerdemanagement für Studium und Lehre
- Studieren mit Beeinträchtigung